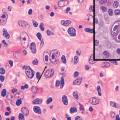

Érythème acral
ERYTHEME ACRAL
Image
Maladie de Bowen
MALADIE DE BOWEN
Image
Syringome
SYRINGOME
Image
Adénocarcinome polymorphe de bas grade
ADENOCARCINOME
TUMEURS DE LA BOUCHE
Image
Chéilite traumatique
CHEILITE
LEVRES
Image
Lentigo actinique
LENTIGO
PHOTOEXPOSITION
Image
Chondrodermatite nodulaire chronique
CHONDERMATITE NODULAIRE
OREILLE
Image
Myosite ossifiante circonscrite
MYOSITE OSSIFIANTE CIRCONSCRITE
Image
Ephélides iriennes
IRIS
MELANOSE
Image
Psoriasis en plaques profus.
DIAGNOSTIC
EVALUATION DES SYMPTOMES
PSORIASIS
Image
Lymphome hodgkinien
MALADIE DE HODGKIN
HISTOLOGIE
Image
Endométriose et kyste ovarien endométriosique
KYSTES DE L'OVAIRE
ENDOMETRIOSE
Image
Endométriose kystique ovarienne ou endométriome
KYSTES DE L'OVAIRE
ENDOMETRIOSE
Image
Chondrocalcinose articulaire
ARTHROPATHIES A CRISTAUX
Image
Arthrite microcristalline (cristaux d'urate de sodium et pyrophosphate de calcium)
ARTHROPATHIES A CRISTAUX
Image
Calcifications méniscales bilatérales
ARTHROPATHIES A CRISTAUX
Image
Chondrocalcinose
ARTHROPATHIES A CRISTAUX
Image
Panaris évolué
INFECTIONS DES TISSUS MOUS
PARONYCHIE
Image
Lipoatrophie des fesses
LIPODYSTROPHIE
Image
Image
Image
Image